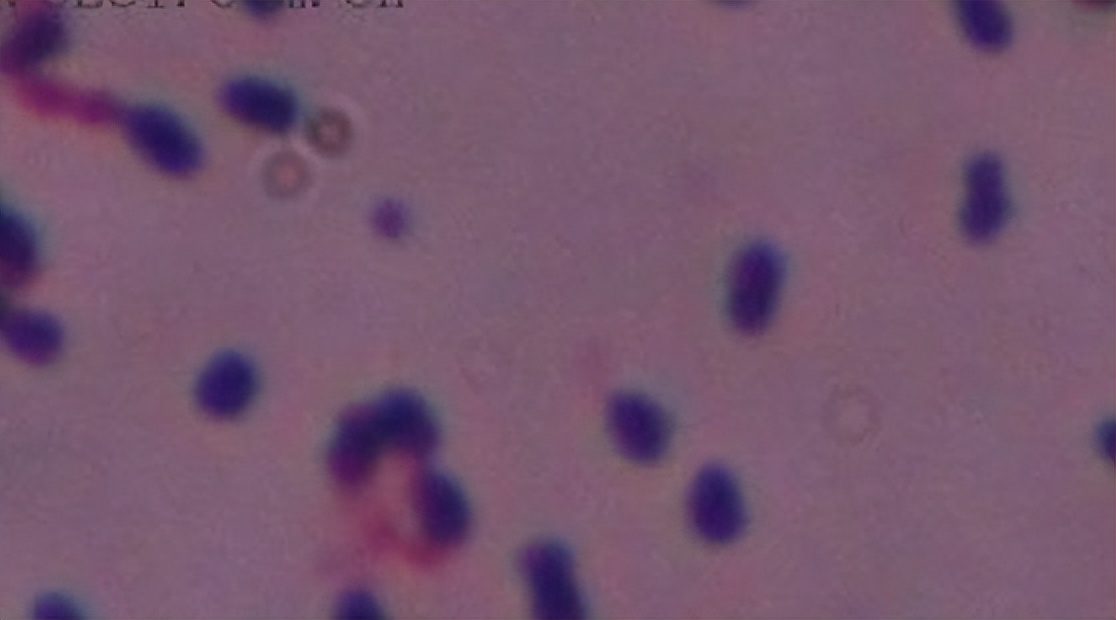
世界上最致命的病毒九种,细菌和病毒哪个更致命

1、埃博拉病毒

彩色透射电子显微镜下的埃博拉病毒:一组令人难以置信的图片揭示了世界上最致命疾病细菌照片,其中包括了黑死病和炭疽病,它们看起来有些像现代艺术作品。即便是致病菌标本也具有一定的危险性,许多标本对人体健康会构成潜在影响,甚至可能造成疾病大流行。虽然细菌等微生物是肉眼所不能看见的,但在显微镜下却可以看到它们。
2、天花病毒

看上去像是一幅油画的天花病毒:图中显示的天花病毒,看上去像是一幅油画,每个病毒的蛋白质衣壳被显示为浅黄色,病毒的遗传物质显示为红色,这幅图像的放大倍率为x28,500。在英国伦敦,这些令人难以置信的图像被用于研究、教育甚至作为艺术品。天花病毒有不同的品种,对人类会造成不同程度的感染。大多数的天花患者会痊愈,死亡情形常发生在发病后1或2周内,约有30%的死亡率。
酷似寿司的天花病毒:图中看起来是一个惊人寿司的东西其实是天花病毒的特写,这种病毒包括遗传物质、DNA(脱氧核糖核酸)、蛋白质衣壳(黄色)等。
3、SARS病毒颗粒

在宿主细胞中的SARS病毒颗粒:SARS病毒粒子呈不规则形状,直径约60-220nm。病毒粒子外包着脂肪膜,膜表面有三种糖蛋白:刺突糖蛋白(S,Spike Protein,是受体结合位点、溶细胞作用和主要抗原位点);小包膜糖蛋白(E,Envelope Protein,较小,与包膜结合的蛋白);膜糖蛋白(M,Membrane Protein,负责营养物质的跨膜运输、新生病毒出芽释放与病毒外包膜的形成)。少数种类还有血凝素糖蛋白(HE蛋白,Haemaglutinin-esterase)。
4、肺炎链球菌

肺炎链球菌可造成上呼吸道感染:来自英国伦敦科学图片图书馆的人员马克阿伯特(Mark Abbott)认为在过去这些难以置信的细菌或病毒图像会进行纯粹的研究。许多都携带着肺炎链球菌,但并不会出现交叉感染,造成免疫系统受损。肺炎链球菌为革兰染色阳性球菌,直径约1m。常呈双排列。菌体成矛头状,宽端相对,尖端向外。在痰、脓液标本中可呈单个或短链状。有毒株在体内形成荚膜。普通染色时荚膜不着色,表现为菌体周围透明环。无鞭毛。不形成芽胞。菌体衰老时,或由于自溶酶(autolysin)的产生将细菌裂解后,可呈现革兰染色阴性。
5、黑死病的细菌
14世纪中叶造成欧洲黑死病的细菌:令人惊叹的图像有助于群众间进行科学方面的沟通,尤其是儿童。图中显示的在14世纪中叶造成欧洲黑死病的细菌,同时也于1664年至1665年导致伦敦大瘟疫的流行。
6、大肠杆菌

放大倍数为x17,000的大肠杆菌:在非洲等地区,脊髓灰质炎、天花、埃博拉病毒的携带着生存率小于10%。图中显示的是大肠杆菌,大肠杆菌是人和动物肠道中最著名的一种细菌,主要寄生于大肠内,约占肠道菌中的1%。是一种两端钝圆、能运动、无芽孢的革兰氏阴性短杆菌。大肠杆菌能合成维生素B和K,正常栖居条件下不致病;若进入胆囊、膀胱等处可引起炎症。在水和食品中检出,可认为是被粪便污染的指标。大肠菌群数常作为饮水、食物或药物的卫生学标准。
7、炭疽菌

炭疽菌芽孢杆菌恐怖的照片:炭疽菌是炭疽病致病的原因,本张图片的放大倍数为x18,300。疽杆菌菌体粗大,两端平截或凹陷,是致病菌中最大的细菌。排列似竹节状,无鞭毛,无动力,革兰氏染色阳性,本菌在氧气充足,温度适宜(25~30℃)的条件下易形成芽胞,炭疽杆菌受低浓度青霉素作用,菌体可肿大形成圆珠,称为串珠反应。这也是炭疽杆菌特有的反应。
8、肺结核菌

被肺结核菌感染后可能是致命的:放大倍率x10,000下的肺结核菌,为细长略带弯曲的杆菌,大小1~4X0.4m。牛分枝杆菌则比较粗短。分枝杆菌属的细菌细胞壁脂质含量较高,约占干重的60%,特别是有大量分枝菌酸(mycolic acid)包围在肽聚糖层的外面,可影响染料的穿入。
9、伯氏疏螺旋体螺旋菌

彩色扫描电子显微镜下的伯氏疏螺旋体螺旋菌:伯氏疏螺旋体螺旋菌在彩色扫描电子显微镜下清晰可见,通过蜱的叮咬进行传播而导致莱姆病的发生。细长、柔软、弯曲呈螺旋状的运动活泼的单细胞原核生物。全长3~500微米,具有细菌细胞的所有内部结构。由核区和细胞质构成原生质圆柱体,柱体外缠绕着一根或多根轴丝。
10、乳头状瘤病毒

人类乳头状瘤病毒的伪*图色**:人类乳头瘤病毒(HPV)在放大倍率x60,000下可看到病毒衣壳包含了72个病毒壳微体,蛋白质单位则显示为一个点。乳头状瘤病毒(papillomavirus,HPV)是一种嗜上皮性病毒,在人和动物中分布广泛,有高度的特异性。人类乳头状瘤病毒(Human papillomavirus,HPV)的宿主为人类故冠以人(human)之称。
11、脑膜炎奈瑟氏菌

导致脑膜炎的脑膜炎奈瑟氏菌细菌:早在911袭击事件后,致命的炭疽疾病引发了大范围的恐慌,图中显示的为彩色扫描电子显微镜 (SEM)拍摄的脑膜炎奈瑟氏菌细菌,它是流行性脑脊髓膜炎的病原菌。多数人感染后表现为带菌状态或隐性感染。只有少数人发展成流行性脑脊髓膜炎。引起脑膜炎的主要是A群菌,B群常为带菌状态。尚有少数是C群菌株。主要表现发热,皮肤瘀斑,脑膜刺激症状。,本张图像放大倍数为x33000。